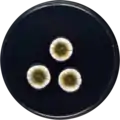
Aspergillus puulaauensis growing on CYA plate
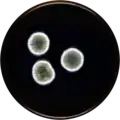
Aspergillus puulaauensis growing on MEAOX plate

| Aspergillus puulaauensis | |
|---|---|
| Scientific classification | |
| Domain: | Eukaryota |
| Kingdom: | Fungi |
| Division: | Ascomycota |
| Class: | Eurotiomycetes |
| Order: | Eurotiales |
| Family: | Aspergillaceae |
| Genus: | Aspergillus |
| Species: | A. puulaauensis |
| Binomial name | |
| Aspergillus puulaauensis Jurjević, S.W. Peterson & B.W. Horn (2012)[1] | |
Aspergillus puulaauensis is a species of fungus in the genus Aspergillus. It is from the Versicolores section.[1][2] The species was first described in 2012.[1]
Growth and morphology
A. puulaauensis has been cultivated on both Czapek yeast extract agar (CYA) plates and Malt Extract Agar Oxoid® (MEAOX) plates. The growth morphology of the colonies can be seen in the pictures below.
Aspergillus puulaauensis growing on CYA plate
Aspergillus puulaauensis growing on CYA plate Aspergillus puulaauensis growing on MEAOX plate
Aspergillus puulaauensis growing on MEAOX plate
References
- 1 2 3 Jurjevic, Zeljko; Peterson, Stephen W.; Horn, Bruce W. (2012). "Aspergillus section Versicolores: nine new species and multilocus dNA sequence based phylogeny". IMA Fungus. 3 (1): 59–795. doi:10.5598/imafungus.2012.03.01.07. ISSN 2210-6340. PMC 3399103. PMID 23155501.
- ↑ Siqueira, J.P.Z.; Sutton, D.A.; Garcia, D.; Gené, J.; Thomson, P.; Wiederhold, N.; Guarro, J. (2016). "Species diversity of Aspergillus section Versicolores in clinical samples and antifungal susceptibility". Fungal Biology. 120 (11): 1458–1467. doi:10.1016/j.funbio.2016.02.006. PMID 27742099.
Further reading
- Gutarowska B, Skóra J, Stępień L, Twarużek M, Błajet-Kosicka A, Otlewska A, Grajewski J (2014). "Estimation of fungal contamination and mycotoxin production at workplaces in composting plants, tanneries, archives and libraries". World Mycotoxin Journal. 7 (3): 345–355. doi:10.3920/WMJ2013.1640.
- Jurjević Ž, Peterson SW, Solfrizzo M, Peraica M (2013). "Sterigmatocystin production by nine newly described Aspergillus species in section Versicolores grown on two different media". Mycotoxin Research. 29 (3): 141–5. doi:10.1007/s12550-013-0160-4. PMID 23417508. S2CID 14676310.
External links
This article is issued from Wikipedia. The text is licensed under Creative Commons - Attribution - Sharealike. Additional terms may apply for the media files.